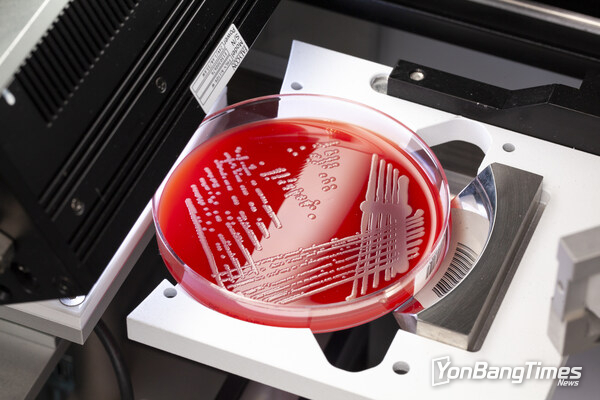

2월 17일 코판 그룹(Copan Group)이 자사의 전면 검사실 자동화 솔루션인 WASPLab®과 함께 사용되는 자동 이미지 판독 소프트웨어 PhenoMATRIX®가 미국에서 2등급 의료기기로 FDA 510(k) 승인을 획득했다고 발표했다.

PhenoMATRIX는 인공지능(AI)과 검사실에서 정의한 규칙 및 임상 정보를 결합해 세균 배양 플레이트 이미지를 자동으로 분류하는 체외 진단 소프트웨어로, 검사실 전문가는 이 소프트웨어를 활용해 전문적 감독을 유지하면서 효율적으로 플레이트를 판독할 수 있다.
이번에 승인된 사용 목적에는 혈액 한천, 초콜릿 한천, 맥콘키 한천(MacConkey agar) 및 CHROMagar orientation 배양 배지 플레이트가 포함된다. 이를 통해 미생물 성장 감지, 집락 수 추정, 표현형 집락 특성에 따른 분리균 감별을 통해 반정량적 및 정성적 이미지 기반 분석을 수행할 수 있다.
코판 다이애그노스틱스(Copan Diagnostics)의 파브리치오 마조키(Fabrizio Mazzocchi) 최고경영자(CEO)는 "이번 승인은 코판과 미국 내 미생물 검사실에 있어 중대한 이정표"라며 "PhenoMATRIX는 수년간의 과학적 개발과 실제 현장 데이터를 기반으로 검사실과 환자 진료 현장을 지원한다"고 밝혔다.
PhenoMATRIX는 그동안 미국 외 지역에서 자동 이미지 검토 및 자동 결과 보고 워크플로를 포함한 코판의 전면 검사실 자동화 솔루션의 일환으로 전 세계에서 사용됐으며, 이번 승인을 통해 숙련된 검사실 인력이 최종 이미지 평가 및 결과 판정을 수행하는 미국에서 그 공식 사용 목적이 확립됐다.
특히 이번 FDA 승인 사용 목적은 단일 애플리케이션 알고리즘을 넘어 다양한 배지 플레이트 유형을 지원하고 환자 데이터와 이미지 분석을 통합해 임상 미생물학 검토를 지원하는 범위의 확장을 의미한다.
코판의 자동화 사업부인 코판 와스프(Copan WASP)의 마리오 사바레세(Mario Savarese) CEO는 "이번 성과는 특별한 협업의 결과"라며 "이번 승인 신청을 위해 규제, 연구개발(R&D), 학술, 품질, 상업 부문 팀이 헌신적으로 노력했다. 이는 코판의 장기적 비전과 팀의 헌신을 입증하는 결과다"라고 말했다.
코판은 PhenoMATRIX의 적용 범위와 배지 유형을 추가로 확대하기 위한 향후 승인 절차에도 지속적으로 투자할 계획이며, 임상 미생물학 커뮤니티와의 파트너십을 바탕으로 혁신을 이어갈 방침이다.
자세한 정보는 copanusa.com을 방문하면 확인할 수 있다.
코판 다이애그노스틱스 소개
코판 다이애그노스틱스는 채취 및 운송 시스템 분야의 선도 제조업체인 코판 그룹의 일원이다. 코판은 협업 중심 접근 방식을 통해 FLOQSwabs®, ESwab®, UTM® Universal Transport Medium™, 그리고 인공지능을 갖춘 전면 검사실 자동화 시스템인 WASPLab®과 같은 혁신적인 기술을 개발했다. 코판은 채취 및 운송 시스템과 검사실 자동화 분야의 혁신을 지속하며, 의료 서비스 제공자가 환자 치료의 질을 개선할 수 있도록 지원하고 있다.